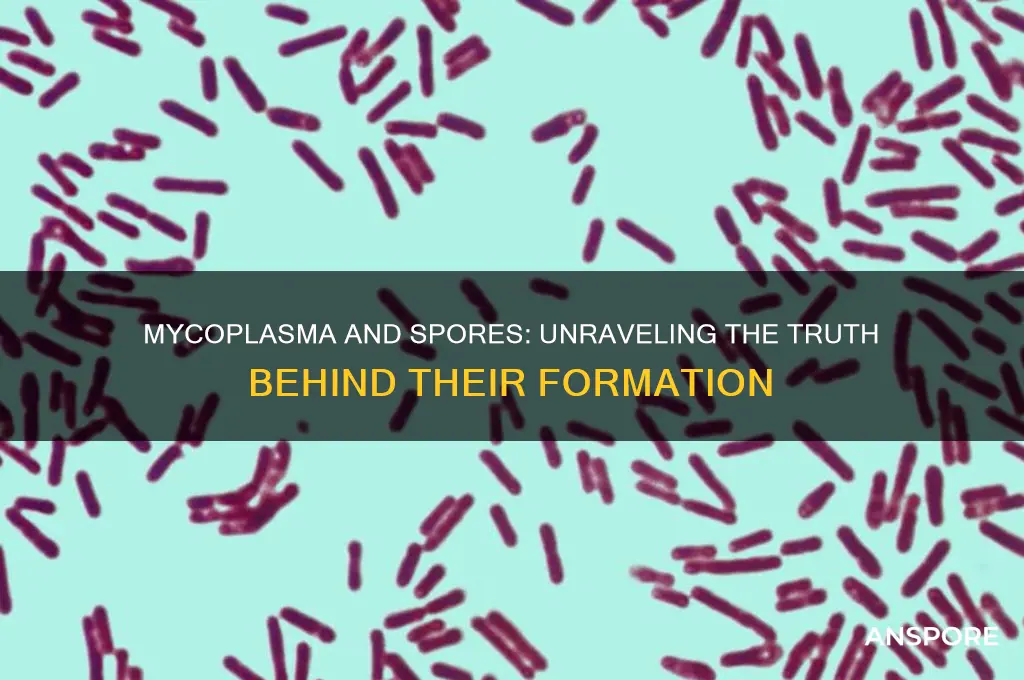
does mycoplasma form spores

Mycoplasma, a genus of bacteria known for its unique characteristics, lacks a cell wall and is among the smallest self-replicating organisms. Unlike many other bacteria, mycoplasma does not form spores, which are dormant, highly resistant structures that allow some bacteria to survive harsh environmental conditions. Instead, mycoplasma relies on its ability to adapt to its environment and persist in host organisms, often causing infections in humans, animals, and plants. The absence of spore formation in mycoplasma is a key distinction from spore-forming bacteria, influencing its survival strategies and treatment approaches.
| Characteristics | Values |
|---|---|
| Does Mycoplasma form spores? | No |
| Reason | Mycoplasma lacks a cell wall, which is necessary for spore formation. Spores are typically formed by bacteria with cell walls as a survival mechanism. |
| Survival mechanisms | Mycoplasma relies on other methods for survival, such as: 1. Adherence to host cells 2. Antigenic variation 3. Formation of biofilms |
| Cell wall presence | Absent (Mycoplasma has a plasma membrane instead) |
| Relevance to spore formation | The absence of a cell wall makes spore formation impossible in Mycoplasma |
| Comparative analysis | Unlike spore-forming bacteria (e.g., Bacillus, Clostridium), Mycoplasma cannot withstand harsh environmental conditions through spore formation |
| Latest research (as of 2023) | No evidence suggests Mycoplasma has evolved to form spores, and its survival strategies remain focused on host-dependent mechanisms |
Explore related products
$17.93 $22.99
What You'll Learn
- Mycoplasma's Lack of Cell Wall: Unlike spore-forming bacteria, mycoplasma lacks a cell wall, preventing spore formation
- Survival Mechanisms: Mycoplasma relies on host cells and biofilms for survival, not spore production
- Environmental Resistance: Without spores, mycoplasma is vulnerable to environmental stressors like desiccation
- Comparison to Sporulating Bacteria: Spores are absent in mycoplasma, unlike Bacillus or Clostridium species
- Laboratory Detection: Mycoplasma contamination is detected via PCR or culture, not spore-based methods

Mycoplasma's Lack of Cell Wall: Unlike spore-forming bacteria, mycoplasma lacks a cell wall, preventing spore formation
Mycoplasmas are unique among bacteria due to their lack of a cell wall, a feature that fundamentally distinguishes them from spore-forming bacteria. This absence of a rigid structure is not merely a trivial detail but a critical factor that prevents mycoplasmas from forming spores. Spore formation, a survival mechanism employed by certain bacteria to endure harsh environmental conditions, relies on the presence of a cell wall to initiate and complete the process. Without this essential component, mycoplasmas are structurally incapable of undergoing the complex morphological changes required for sporulation.
To understand the implications of this, consider the spore-forming process in bacteria like *Bacillus* and *Clostridium*. These organisms synthesize a protective spore coat and cortex, layers that depend on the cell wall as a foundation. Mycoplasmas, however, possess only a plasma membrane, which lacks the structural integrity to support such transformations. This biological limitation not only restricts their survival strategies but also influences their susceptibility to antibiotics, as many drugs target the cell wall synthesis pathway—a pathway mycoplasmas do not possess.
From a practical standpoint, the inability of mycoplasmas to form spores has significant implications in laboratory and clinical settings. For instance, mycoplasma contamination in cell cultures is notoriously difficult to eradicate because these organisms can evade detection and persist in nutrient-rich environments. Unlike spore-forming bacteria, which can be inactivated by heat or chemical treatments targeting spores, mycoplasmas require specific antibiotics like tetracyclines or macrolides for control. Researchers must adhere to strict protocols, including regular mycoplasma testing and the use of 0.1% Mycoplasma Removal Agent (MRA) in culture media, to prevent contamination.
Comparatively, the lack of a cell wall in mycoplasmas also affects their interaction with the host immune system. Without a peptidoglycan layer, they evade recognition by certain immune receptors, allowing them to establish chronic infections. This contrasts sharply with spore-forming bacteria, whose spores can trigger immune responses upon germination. For example, in patients with compromised immunity, mycoplasmas like *Mycoplasma pneumoniae* can cause persistent respiratory infections, often requiring prolonged treatment with azithromycin (500 mg on day 1, followed by 250 mg daily for 4 days) to achieve clearance.
In conclusion, the absence of a cell wall in mycoplasmas is not just a structural anomaly but a defining characteristic that precludes spore formation and shapes their behavior in both natural and laboratory environments. This distinction underscores the importance of tailored strategies for managing mycoplasma infections and contamination, highlighting the need for continued research into their unique biology and vulnerabilities.
Moss Spores' Protective Coat: Unveiling Nature's Tiny Armor Secrets
You may want to see also

Survival Mechanisms: Mycoplasma relies on host cells and biofilms for survival, not spore production
Mycoplasma, the smallest known bacteria capable of self-replication, lacks a cell wall—a trait that distinguishes it from many other bacterial species. This unique characteristic also means it cannot form spores, a survival strategy employed by some bacteria to endure harsh environmental conditions. Instead, Mycoplasma relies on two primary mechanisms to ensure its persistence: host cell dependence and biofilm formation. Understanding these strategies is crucial for combating infections caused by these microorganisms, as they often evade traditional antibiotic treatments.
Host cell dependence is a cornerstone of Mycoplasma’s survival. Unlike spore-forming bacteria that can lie dormant for extended periods, Mycoplasma requires a living host to thrive. It attaches to host cell membranes, extracting nutrients and energy while evading the immune system. For instance, *Mycoplasma pneumoniae*, a common respiratory pathogen, binds to respiratory epithelial cells, causing inflammation and tissue damage. This reliance on host cells makes Mycoplasma particularly challenging to eradicate, as it hides within the host’s own tissues. To combat such infections, antibiotics like macrolides (e.g., azithromycin, 500 mg on day 1 followed by 250 mg daily for 4 days) or tetracyclines (e.g., doxycycline, 100 mg twice daily for 7–14 days) are often prescribed, targeting the bacteria’s metabolic processes.
Biofilm formation is another critical survival mechanism for Mycoplasma. Biofilms are structured communities of microorganisms encased in a self-produced extracellular matrix, providing protection against antibiotics, host defenses, and environmental stressors. Mycoplasma species, such as *Mycoplasma genitalium*, form biofilms on mucosal surfaces, enhancing their resistance to treatment. For example, in urogenital infections, biofilms can shield *M. genitalium* from azithromycin, leading to treatment failure. To address this, combination therapy or longer treatment durations (e.g., moxifloxacin, 400 mg daily for 7–14 days) may be necessary to penetrate the biofilm and eliminate the bacteria.
Comparatively, spore-forming bacteria like *Bacillus anthracis* can survive extreme conditions by forming endospores, which are highly resistant to heat, radiation, and desiccation. Mycoplasma, however, lacks this ability, making it more vulnerable to environmental changes outside a host. This vulnerability underscores the importance of its reliance on host cells and biofilms for survival. While spore-forming bacteria can persist in soil or water for decades, Mycoplasma’s survival is intrinsically tied to its ability to exploit host resources and form protective biofilms.
In practical terms, preventing Mycoplasma infections involves minimizing exposure to potential sources, such as contaminated medical equipment or close contact with infected individuals. For healthcare settings, rigorous sterilization protocols are essential, as Mycoplasma can survive on surfaces for short periods. Additionally, early diagnosis and appropriate antibiotic treatment are critical to prevent chronic infections, particularly in immunocompromised individuals or those with underlying respiratory conditions. By understanding Mycoplasma’s unique survival mechanisms, clinicians and researchers can develop more effective strategies to combat these persistent pathogens.
Do Yeast Produce Ascus Spores? Unraveling Fungal Reproduction Mysteries
You may want to see also

Environmental Resistance: Without spores, mycoplasma is vulnerable to environmental stressors like desiccation
Mycoplasma, the smallest known bacteria capable of self-replication, lacks a cell wall and, crucially, the ability to form spores. This absence of spores leaves mycoplasma highly susceptible to environmental stressors, particularly desiccation. Unlike spore-forming bacteria such as Bacillus or Clostridium, which can enter a dormant, resilient state to survive harsh conditions, mycoplasma relies on its host or a nutrient-rich environment for survival. When exposed to dry conditions, mycoplasma’s fragile cell membrane rapidly loses integrity, leading to cell lysis and death. This vulnerability is a double-edged sword: while it limits mycoplasma’s environmental persistence, it also makes it less likely to survive outside a host for extended periods, reducing its transmission potential in certain settings.
To understand the practical implications, consider a laboratory setting where mycoplasma contamination is a persistent concern. Without spores, mycoplasma cannot survive standard sterilization techniques like autoclaving or prolonged exposure to desiccating agents such as ethanol. However, its small size allows it to evade filtration systems, and its resistance to antibiotics lacking cell wall targets (e.g., penicillin) complicates eradication. Researchers must therefore employ stringent aseptic techniques, including the use of 70% ethanol for surface disinfection and regular testing of cell cultures for mycoplasma contamination. For example, PCR-based detection kits can identify mycoplasma at concentrations as low as 10^3 cells/mL, ensuring early intervention before contamination spreads.
From a comparative perspective, the inability of mycoplasma to form spores contrasts sharply with spore-forming pathogens like *Bacillus anthracis*, which can survive in soil for decades. This difference highlights the evolutionary trade-offs between persistence and host dependency. Mycoplasma’s vulnerability to desiccation limits its environmental reservoir but necessitates a host for survival, making it a primarily opportunistic pathogen. In clinical settings, this means mycoplasma infections (e.g., *Mycoplasma pneumoniae*) are typically acquired through close contact rather than environmental exposure. Patients, particularly children and young adults, are more susceptible during outbreaks in crowded environments like schools or military barracks.
For those managing mycoplasma in industrial or research contexts, leveraging its environmental vulnerabilities can be a strategic advantage. Desiccation-based methods, such as lyophilization (freeze-drying), are ineffective for long-term storage of mycoplasma due to its fragility, but they can be used to rapidly inactivate it on surfaces. Alternatively, ultraviolet (UV) radiation and hydrogen peroxide vapor are effective disinfectants, as mycoplasma lacks the spore-like protection to withstand these stressors. In animal husbandry, where mycoplasma contamination can devastate livestock, maintaining humidity levels below 40% in storage areas can reduce survival rates, though this must be balanced with the needs of the animals themselves.
In conclusion, the absence of spore formation in mycoplasma renders it acutely vulnerable to desiccation and other environmental stressors, shaping its ecology and management strategies. While this limits its persistence outside hosts, it also demands targeted approaches to detection and control. By understanding these vulnerabilities, researchers, clinicians, and industry professionals can mitigate the risks posed by mycoplasma more effectively, whether in the lab, clinic, or field.
Oxone's Power: Can It Effectively Eliminate Mold Spores?
You may want to see also
Explore related products

Comparison to Sporulating Bacteria: Spores are absent in mycoplasma, unlike Bacillus or Clostridium species
Mycoplasma, the smallest known bacteria capable of self-replication, lacks a cell wall and spores, setting it apart from sporulating bacteria like Bacillus and Clostridium. These latter species are renowned for their ability to form highly resistant endospores, which allow them to survive extreme conditions such as heat, desiccation, and radiation. In contrast, mycoplasma’s survival strategies rely on its ability to inhabit protected environments, such as host organisms, rather than producing spores. This fundamental difference in structure and survival mechanisms highlights the unique evolutionary adaptations of mycoplasma compared to its spore-forming counterparts.
To understand the implications of this distinction, consider the practical challenges in sterilizing environments contaminated with sporulating bacteria versus mycoplasma. Bacillus and Clostridium spores require extreme measures, such as autoclaving at 121°C for 15–30 minutes or the use of sporicidal chemicals like bleach, to ensure eradication. Mycoplasma, however, is more susceptible to standard disinfection methods due to its lack of a cell wall and spores. For instance, ethanol (70%) or quaternary ammonium compounds effectively eliminate mycoplasma from surfaces, whereas these agents would fail against Bacillus or Clostridium spores. This underscores the importance of identifying the contaminant to apply the appropriate sterilization protocol.
From an analytical perspective, the absence of spores in mycoplasma also influences its role in laboratory and clinical settings. Mycoplasma contamination in cell cultures, for example, is notoriously difficult to detect due to its small size and lack of visible colony formation on standard agar plates. However, its inability to form spores means it cannot persist in dormant states outside a host for extended periods, unlike Bacillus or Clostridium. Researchers must therefore focus on preventing mycoplasma contamination through rigorous aseptic techniques and routine testing, rather than worrying about spore-mediated survival. This targeted approach is essential for maintaining the integrity of experimental results.
Persuasively, the comparison between mycoplasma and sporulating bacteria like Bacillus and Clostridium reveals the importance of understanding microbial survival strategies in both medical and industrial contexts. While Bacillus and Clostridium spores pose significant challenges in food preservation, healthcare, and biodefense due to their resilience, mycoplasma’s lack of spores limits its environmental persistence but increases its reliance on host-dependent survival. This distinction informs the development of targeted interventions, such as spore-specific disinfectants for Bacillus and Clostridium or mycoplasma-specific PCR assays for contamination detection. By recognizing these differences, professionals can implement more effective strategies to control and mitigate microbial risks.
Finally, a descriptive exploration of these bacteria reveals the elegance of their adaptations. Bacillus and Clostridium spores are marvels of nature, encapsulating genetic material within a protective coat to endure harsh conditions. Mycoplasma, on the other hand, thrives through minimalism, shedding even a cell wall to achieve its tiny size and parasitic lifestyle. While spores enable long-term survival in adverse environments, mycoplasma’s success lies in its ability to exploit host resources. This contrast not only illustrates the diversity of bacterial survival strategies but also emphasizes the need for tailored approaches in managing these microorganisms, whether in the lab, clinic, or industry.
Can X-Rays Detect Fungal Spores in the Lungs? Explained
You may want to see also

Laboratory Detection: Mycoplasma contamination is detected via PCR or culture, not spore-based methods
Mycoplasma, the smallest known bacteria capable of self-replication, lacks a cell wall and cannot form spores. This fundamental biological characteristic dictates the methods used for its detection in laboratory settings. Unlike spore-forming bacteria, which can be identified through spore-staining techniques or heat-shock activation, mycoplasma contamination relies on entirely different approaches. PCR (polymerase chain reaction) and culture-based methods are the gold standards for detecting these elusive microorganisms.
Understanding this distinction is crucial for researchers and clinicians alike. Misidentifying mycoplasma contamination due to reliance on spore-based detection methods can lead to inaccurate results, compromised experiments, and potentially harmful clinical outcomes.
PCR: The Molecular Detective
PCR stands as a powerful tool for mycoplasma detection due to its sensitivity and specificity. This technique amplifies specific DNA sequences unique to mycoplasma, allowing for their identification even at very low concentrations. Commercially available PCR kits often target conserved genes like 16S rRNA, ensuring broad-spectrum detection across various mycoplasma species. A typical PCR protocol involves DNA extraction from the sample, amplification using specific primers, and visualization of the amplified product through gel electrophoresis. While PCR offers high sensitivity, it's crucial to follow strict contamination prevention protocols to avoid false positives.
Culture: The Traditional Approach
Culturing mycoplasma requires specialized agar plates or broth media supplemented with nutrients and antibiotics to inhibit the growth of contaminating bacteria. Mycoplasma colonies are typically small, fry-like, and may take several days to become visible. Experienced microbiologists can often identify mycoplasma based on colony morphology, but confirmation through further testing, such as PCR or immunological assays, is recommended for accurate species identification.
The absence of spores in mycoplasma renders spore-based detection methods ineffective. Techniques like spore staining, heat shock activation, and spore germination assays are designed to target the unique properties of spore-forming bacteria. Applying these methods to mycoplasma will yield negative results, leading to false conclusions about the presence or absence of contamination.
Practical Considerations
Regular mycoplasma testing is essential for cell culture laboratories and research facilities to ensure the integrity of experiments and the reliability of results. The choice between PCR and culture depends on factors like sensitivity requirements, turnaround time, and available resources. PCR offers rapid results and high sensitivity, while culture provides visual confirmation and allows for further characterization of the mycoplasma strain.
By understanding the unique characteristics of mycoplasma and employing appropriate detection methods, researchers and clinicians can effectively identify and mitigate contamination, ensuring the accuracy and reliability of their work.
Spraying Spores with Alcohol: Effective Disinfection or Risky Practice?
You may want to see also
Frequently asked questions
No, Mycoplasma does not form spores. It is a type of bacteria that lacks a cell wall and does not produce spores as part of its life cycle.
Mycoplasma lacks the genetic and structural mechanisms required for spore formation. Its unique cell wall-less structure and small genome limit its ability to undergo sporulation.
While Mycoplasma does not form spores, it can survive in certain harsh conditions due to its adaptability and ability to persist in host environments. However, it is generally more vulnerable to environmental stresses compared to spore-forming bacteria.































